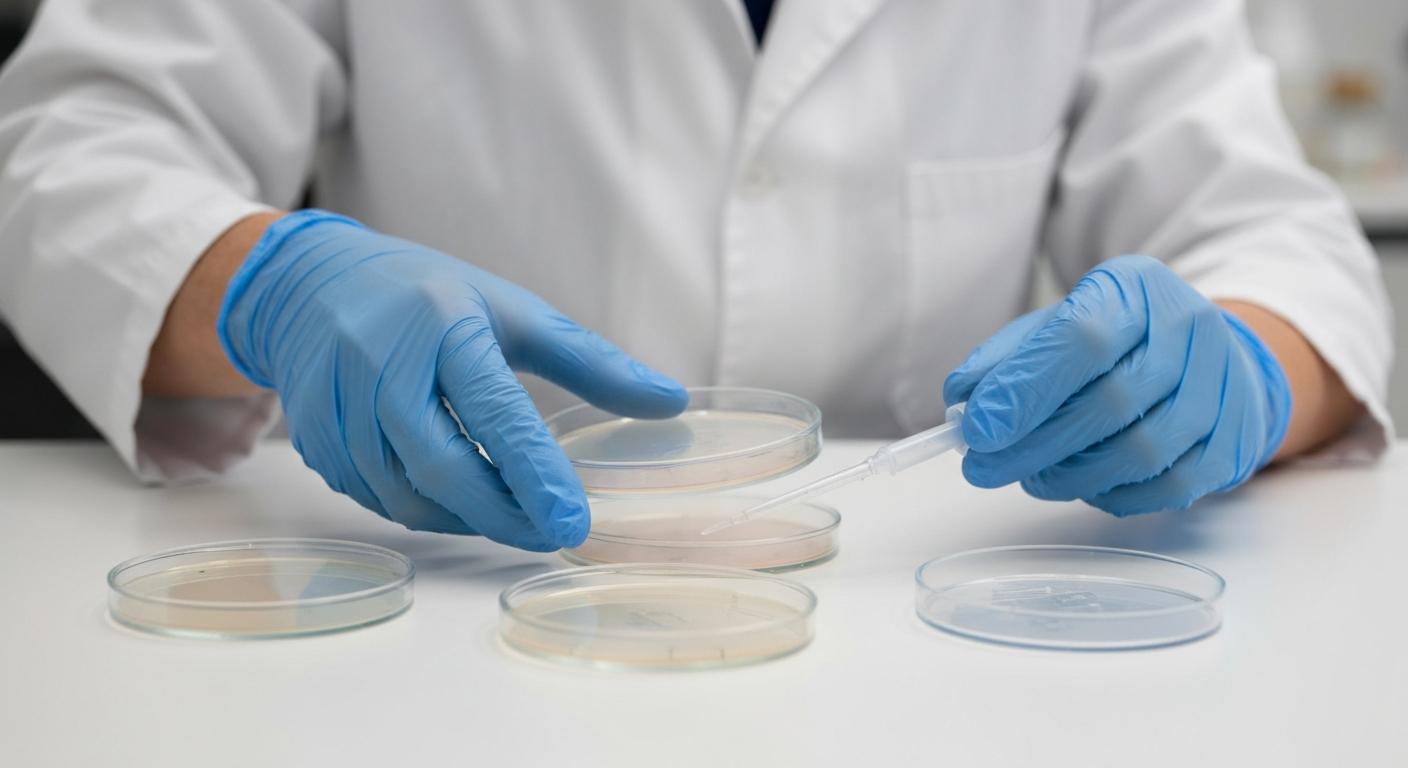
Guida alla lettura di un antibiogramma

Capire come leggere correttamente un antibiogramma è una competenza centrale nella pratica clinica moderna, non solo per gli specialisti in microbiologia ma anche per medici di reparto, medici di medicina generale e professionisti sanitari coinvolti nella prescrizione di antibiotici. Un’interpretazione accurata consente di scegliere la terapia più mirata possibile, ridurre l’uso inappropriato di antibiotici ad ampio spettro e contribuire alla lotta contro l’antibiotico‑resistenza, oggi riconosciuta come una delle principali minacce per la salute pubblica globale.
Questa guida offre una panoramica pratica e ragionata su cosa sia un antibiogramma, come vengono presentati i risultati, quali sono i concetti chiave di sensibilità e resistenza, quali errori interpretativi evitare e come integrare le informazioni del laboratorio nel ragionamento clinico quotidiano. L’obiettivo non è sostituire le linee guida ufficiali o il parere dello specialista, ma fornire uno schema di lettura strutturato e aggiornato, utile sia a chi si avvicina per la prima volta a questo strumento, sia a chi desidera affinare la propria capacità di interpretazione.
Cos’è un antibiogramma
L’antibiogramma è un test di laboratorio che valuta la sensibilità o la resistenza di un microrganismo (batterio, più raramente lievito) a diversi antibiotici. In pratica, a partire da un campione clinico (sangue, urine, espettorato, liquido cefalorachidiano, materiale da ferita, ecc.) il laboratorio isola il patogeno responsabile dell’infezione e ne studia il comportamento in presenza di concentrazioni note di vari antimicrobici. Il risultato viene poi riportato in forma tabellare, con l’elenco degli antibiotici testati e, per ciascuno, un giudizio qualitativo (ad esempio S, I, R) e spesso un dato quantitativo (come la MIC, concentrazione minima inibente).
Dal punto di vista tecnico, l’antibiogramma può essere eseguito con diversi metodi standardizzati. I più diffusi sono la diffusione su disco (metodo Kirby‑Bauer), in cui dischetti impregnati di antibiotico vengono posti su una piastra con il batterio e si misura il diametro dell’alone di inibizione, e i metodi di determinazione della MIC (broth microdilution, gradienti su striscia, sistemi automatizzati), che individuano la più bassa concentrazione di antibiotico in grado di inibire la crescita. I risultati grezzi (millimetri di alone o mg/L di MIC) vengono poi tradotti in categorie cliniche secondo criteri internazionali.
Queste categorie sono definite da organismi di riferimento come EUCAST (European Committee on Antimicrobial Susceptibility Testing) o CLSI (Clinical and Laboratory Standards Institute), che stabiliscono i cosiddetti breakpoint, cioè le soglie di diametro o MIC che separano un ceppo “sensibile” da uno “resistente” o “a sensibilità aumentata”. È importante sottolineare che l’antibiogramma non misura direttamente l’efficacia clinica del trattamento nel singolo paziente, ma fornisce una stima standardizzata della probabilità che un determinato antibiotico raggiunga concentrazioni efficaci nel sito di infezione con i dosaggi abituali.
Oltre agli antibiogrammi “individuali”, riferiti al singolo isolato di un paziente, esistono gli antibiogrammi cumulativi, che aggregano i dati di suscettibilità di molti isolati raccolti in un certo periodo in un ospedale o in un reparto. Questi strumenti epidemiologici sono fondamentali per guidare la terapia empirica (prima dell’arrivo del risultato individuale) e per monitorare l’andamento della resistenza nel tempo. La lettura di un antibiogramma, quindi, si colloca sempre in un contesto più ampio: quello della sorveglianza microbiologica e della antimicrobial stewardship, cioè l’uso responsabile degli antibiotici a livello di sistema.
Interpretazione dei risultati
Il primo passo per interpretare un antibiogramma è comprendere il significato delle sigle più comuni, in particolare S, I e R. “S” indica che il microrganismo è considerato sensibile all’antibiotico, cioè che, con i dosaggi standard e nelle condizioni usuali, è probabile ottenere concentrazioni sufficienti a inibire il patogeno. “R” indica resistenza, ovvero che, anche aumentando la dose entro i limiti di sicurezza, è improbabile raggiungere livelli efficaci. La categoria “I”, che nelle classificazioni più recenti è spesso definita come “Susceptible, Increased exposure”, non significa semplicemente “intermedio”, ma suggerisce che l’antibiotico può essere efficace solo se si ottiene un’esposizione più elevata (ad esempio con dosi maggiori, intervalli più ravvicinati o concentrazioni più alte nel sito di infezione).
Accanto a queste categorie qualitative, molti referti riportano la MIC (Minimum Inhibitory Concentration), espressa in mg/L (o µg/mL). Una MIC bassa indica che il batterio è inibito da concentrazioni ridotte di antibiotico, mentre una MIC alta suggerisce la necessità di livelli più elevati. Tuttavia, la MIC non va interpretata in modo assoluto: una MIC di 1 mg/L può essere considerata “sensibile” per un antibiotico e “resistente” per un altro, a seconda dei breakpoint stabiliti. Inoltre, la MIC è un valore di laboratorio che non tiene conto di fattori clinici come la farmacocinetica (come il farmaco si distribuisce nell’organismo) e la farmacodinamica (come interagisce con il batterio nel tempo).
Un altro elemento cruciale è la relazione tra antibiotici della stessa classe. Ad esempio, un ceppo di Staphylococcus aureus resistente alla meticillina (MRSA) sarà considerato resistente a tutti i beta‑lattamici tradizionali, anche se non testati singolarmente. Analogamente, alcuni pattern di resistenza nei bacilli Gram‑negativi (come la produzione di beta‑lattamasi a spettro esteso, ESBL, o carbapenemasi) permettono di inferire la probabile inefficacia di intere classi di antibiotici. La cosiddetta “lettura interpretativa” dell’antibiogramma consiste proprio nel riconoscere questi pattern fenotipici e nel dedurre meccanismi di resistenza sottostanti, andando oltre la semplice lettura meccanica delle lettere S/I/R.
Infine, è essenziale integrare i dati dell’antibiogramma con il contesto clinico. Un antibiotico classificato come “sensibile” potrebbe non essere appropriato se non raggiunge concentrazioni adeguate nel sito di infezione (ad esempio alcuni farmaci che si concentrano nelle urine ma non nel sangue, o viceversa), se il paziente ha controindicazioni specifiche (allergie, insufficienza renale o epatica, interazioni farmacologiche) o se la via di somministrazione disponibile non è compatibile con la gravità del quadro (ad esempio terapia orale in un paziente in shock settico). L’antibiogramma, quindi, è uno strumento di supporto alla decisione, non un “ordine di terapia” automatico.
Resistenza e sensibilità agli antibiotici
La distinzione tra sensibilità e resistenza agli antibiotici è al centro dell’interpretazione dell’antibiogramma, ma questi concetti sono più sfumati di quanto possa sembrare. La resistenza può essere intrinseca, quando un batterio è naturalmente insensibile a una certa classe di farmaci (ad esempio, molti Gram‑negativi sono intrinsecamente resistenti ai glicopeptidi), oppure acquisita, quando sviluppa nuovi meccanismi di difesa attraverso mutazioni o acquisizione di geni di resistenza (plasmidi, trasposoni, integroni). L’antibiogramma fotografa il risultato finale di questi meccanismi, mostrando se, in condizioni standard, il farmaco riesce o meno a inibire la crescita.
Dal punto di vista pratico, la resistenza può essere mediata da diversi meccanismi: produzione di enzimi che inattivano l’antibiotico (come le beta‑lattamasi), modifiche del bersaglio molecolare (ad esempio alterazioni delle proteine leganti la penicillina), riduzione della permeabilità della membrana esterna o aumento dell’efflusso del farmaco fuori dalla cellula. Alcuni di questi meccanismi conferiscono resistenza a più classi di antibiotici contemporaneamente, dando origine a ceppi multiresistenti (MDR), estensivamente resistenti (XDR) o addirittura pan‑resistenti (PDR). In questi casi, l’antibiogramma mostra spesso un quadro con pochissimi antibiotici classificati come “S”, limitando fortemente le opzioni terapeutiche.
La categoria “sensibile”, d’altra parte, non è sinonimo di “garantito efficace” nel singolo paziente. I breakpoint che definiscono S/I/R sono basati su dati di distribuzione delle MIC, farmacocinetica/farmacodinamica e, quando disponibili, esiti clinici medi. Tuttavia, in alcune situazioni (infezioni profonde, pazienti immunodepressi, cariche batteriche molto elevate, biofilm su protesi o dispositivi) può essere necessario preferire antibiotici con un margine di efficacia più ampio o combinazioni di farmaci, anche se più di un’opzione appare “sensibile” in vitro. Inoltre, la categoria “I” richiede particolare attenzione: un antibiotico “I” può essere una scelta valida se si può garantire un’esposizione aumentata, ma può essere inappropriato in contesti in cui non è possibile ottimizzare dosi e vie di somministrazione.
Un aspetto sempre più rilevante è la resistenza emergente, cioè la comparsa di nuovi meccanismi che modificano rapidamente i profili di sensibilità. Per questo motivo, gli standard di interpretazione vengono periodicamente aggiornati e i laboratori devono adeguare i propri sistemi di lettura. In pratica, un ceppo che alcuni anni fa sarebbe stato classificato come “sensibile” a un certo antibiotico potrebbe oggi rientrare nella categoria “resistente” o “I” alla luce di nuove evidenze. Questo sottolinea l’importanza di considerare l’antibiogramma come un documento dinamico, inserito in un contesto di sorveglianza continua e di aggiornamento delle conoscenze.
Errori comuni nell’interpretazione
Uno degli errori più frequenti è la lettura puramente meccanica delle sigle S/I/R, senza considerare il quadro complessivo. Limitarsi a scegliere “un qualsiasi antibiotico con S” può portare a terapie subottimali, soprattutto se non si tiene conto del sito di infezione, della gravità del quadro clinico e delle caratteristiche farmacocinetiche del farmaco. Ad esempio, un antibiotico con buona attività in vitro ma scarsa penetrazione nel sistema nervoso centrale non sarà la scelta ideale per una meningite, anche se l’antibiogramma lo riporta come “sensibile”. Allo stesso modo, un farmaco con eliminazione prevalentemente renale potrebbe accumularsi in un paziente con insufficienza renale, aumentando il rischio di tossicità.
Un secondo errore comune è ignorare i pattern di resistenza e i meccanismi sottostanti. Alcuni profili di sensibilità apparentemente contraddittori (ad esempio resistenza a un antibiotico di vecchia generazione ma sensibilità a uno più recente della stessa classe, o viceversa) possono indicare la presenza di enzimi specifici o di mutazioni particolari. Senza una lettura interpretativa, il clinico potrebbe scegliere un farmaco che, pur risultando “sensibile” in vitro, è in realtà poco affidabile in presenza di determinati meccanismi di resistenza. In questi casi, la collaborazione con il microbiologo è fondamentale per chiarire il significato del profilo osservato.
Un terzo errore riguarda l’uso improprio della categoria “I”. Considerare “I” come sinonimo di “quasi R” e scartare automaticamente questi antibiotici può privare il clinico di opzioni utili, soprattutto quando è possibile modulare la dose o la via di somministrazione per aumentare l’esposizione. Al contrario, utilizzare un antibiotico “I” senza adeguare lo schema terapeutico (ad esempio mantenendo dosi standard in un’infezione grave) può portare a fallimenti terapeutici. È quindi essenziale comprendere che “I” implica una valutazione più fine del rapporto tra farmacocinetica, farmacodinamica e sito di infezione.
Infine, è frequente sottovalutare l’importanza della qualità del campione e del contesto microbiologico. Un antibiogramma eseguito su un microrganismo che rappresenta una contaminazione (ad esempio alcuni batteri cutanei isolati da emocolture singole) o su flora mista di un campione mal raccolto può indurre a trattamenti inutili o inappropriati. Allo stesso modo, interpretare come patogeni batteri che fanno parte della flora commensale di una certa sede, senza correlazione clinica, può portare a sovra‑trattamento. L’antibiogramma va sempre letto alla luce della probabilità che il microrganismo isolato sia effettivamente il responsabile del quadro infettivo.
Consigli per l’uso clinico
Per utilizzare al meglio l’antibiogramma nella pratica clinica, è utile seguire un percorso di lettura strutturato. Un approccio possibile prevede: 1) identificare il microrganismo e valutarne il potenziale patogeno in quella sede; 2) verificare se si tratta di un batterio noto per particolari meccanismi di resistenza (ad esempio MRSA, Enterococcus faecium, Pseudomonas aeruginosa, Acinetobacter baumannii, Enterobacterales produttori di ESBL o carbapenemasi); 3) esaminare il profilo S/I/R concentrandosi sulle classi di antibiotici più appropriate per il tipo di infezione (es. beta‑lattamici per molte infezioni sistemiche, fluorochinoloni o cotrimossazolo per alcune infezioni urinarie, ecc.); 4) tra le opzioni “sensibili”, scegliere il farmaco con il miglior equilibrio tra efficacia, spettro mirato, sicurezza e via di somministrazione adeguata.
Un altro principio chiave è quello di de‑escalation: iniziare, quando necessario, con una terapia empirica ad ampio spettro in situazioni gravi o ad alto rischio, per poi restringere il trattamento a un antibiotico più mirato non appena disponibili i risultati dell’antibiogramma e del quadro clinico. Questo approccio riduce la pressione selettiva sui batteri e contribuisce a limitare la diffusione di ceppi resistenti. In parallelo, è importante valutare periodicamente la necessità di proseguire la terapia antibiotica, la possibilità di passare da una via endovenosa a una orale e la durata complessiva del trattamento, sempre in accordo con le linee guida e con la risposta clinica del paziente.
La collaborazione tra clinici, microbiologi e farmacisti ospedalieri è essenziale per una corretta interpretazione e applicazione dei dati di suscettibilità. I programmi di antimicrobial stewardship spesso prevedono la revisione congiunta dei casi complessi, la definizione di protocolli condivisi per la gestione delle infezioni più frequenti e la costruzione di antibiogrammi cumulativi specifici per reparto o per tipo di infezione. Questi strumenti consentono di adattare lescelte empiriche alla realtà locale di resistenza e di aggiornare rapidamente le strategie terapeutiche quando emergono nuovi pattern.
Infine, è importante ricordare che l’antibiogramma è solo uno degli elementi del ragionamento clinico globale. Fattori come la stabilità emodinamica del paziente, la presenza di focolai infettivi non drenati, la necessità di interventi chirurgici o di rimozione di dispositivi infetti (cateteri, protesi), lo stato immunitario e le comorbidità influenzano in modo determinante l’esito della terapia. Un antibiotico “perfetto” in vitro può fallire se non si affrontano questi aspetti. Al contrario, un uso ragionato dell’antibiogramma, integrato con una gestione complessiva dell’infezione, può migliorare significativamente gli esiti clinici e contribuire a preservare l’efficacia degli antibiotici nel tempo.
In sintesi, imparare a leggere un antibiogramma significa andare oltre la semplice decodifica di sigle e numeri, per integrare i dati di laboratorio con la conoscenza dei meccanismi di resistenza, delle caratteristiche farmacologiche dei farmaci e del contesto clinico del paziente. Un’interpretazione consapevole consente di scegliere terapie più mirate, ridurre l’uso inappropriato di antibiotici ad ampio spettro e contribuire attivamente alle strategie di contrasto dell’antibiotico‑resistenza. Investire tempo nella comprensione di questo strumento, e nel dialogo con il laboratorio di microbiologia, rappresenta quindi un passo fondamentale verso una pratica clinica più efficace e responsabile.
Per approfondire
CLSI – Reporting of cumulative antimicrobial susceptibility testing data offre una panoramica dettagliata su come costruire e interpretare antibiogrammi cumulativi, con indicazioni pratiche sui requisiti minimi di numero di isolati e sulla presentazione delle percentuali di suscettibilità.
The antibiogram: key considerations for its development and utilization analizza il ruolo degli antibiogrammi nella pratica clinica e nella stewardship antibiotica, con esempi di applicazione per guidare la terapia empirica in diversi contesti assistenziali.
Antimicrobial stewardship and antibiograms discute come integrare i dati di suscettibilità con strumenti di diagnostica rapida e marcatori di resistenza, per ottimizzare la scelta precoce degli antibiotici e ridurre l’uso inappropriato di farmaci ad ampio spettro.
NCBI – Biosample Antibiograms descrive il formato standardizzato con cui vengono registrati i dati di antibiogramma nei database di ricerca, includendo metodo di laboratorio, unità di misura e fenotipo di resistenza, utile per chi si occupa anche di aspetti epidemiologici e di ricerca.
Interpretive reading of the antibiogram approfondisce il concetto di lettura interpretativa, mostrando come riconoscere pattern fenotipici di resistenza e inferire i meccanismi sottostanti per migliorare la scelta terapeutica oltre la semplice lettura S/I/R.